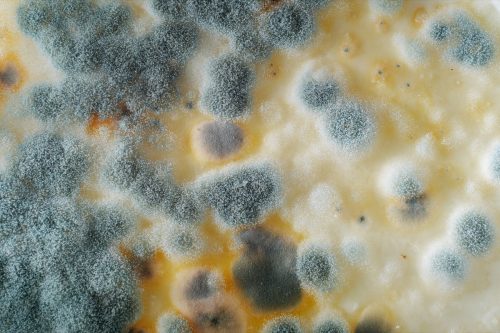

Family Dollar Shopper Claims She Was Sold Moldy Food: “I Feel Like I’m Gonna Die”

Inflation may be improving, but over the past several months, rising prices have encouraged many of us to shop at discount stores to cut down on costs. But saving a buck might not be worth it—at least, not according to one shopper. A Family Dollar customer has taken to social media with the claim that she purchased moldy food at the popular dollar store chain. Read on to find out why she’s now speaking out.
READ THIS NEXT: Walmart, Dollar General, and Family Dollar Are All Under Fire for Overcharging Shoppers.
A shopper is claiming Family Dollar sold her moldy food.
A now-viral TikTok video is making a bold claim about Family Dollar.
On Dec. 15, a TikToker named Kiah, who posts under the username @kiah.kiah22, shared a video to her account showing a moldy Slim Jim Beef and Cheese stick she claims was sold to her by a store in Orlando, Florida.
“I just purchased this Slim Jim from my local Family Dollar. Look at this,” Kiah said, zooming the video in on an opened Slim Jim covered in a number of mold-like spots that appeared white, blue, and black. “This is disgusting.”
The shopper also revealed she had eaten some of the Slim Jim before noticing it was covered in mold. “As you can see, I took a bite out of this Slim Jim,” she said. “I am completely lost for words at the disregard of human life at this point because I feel like I’m gonna die right now.”
Eating moldy food can have health consequences.
If you have food that is covered with mold like the Slim Jim Kiah claims she purchased from a Florida Family Dollar store, the U.S. Department of Agriculture’s (USDA) Food Safety and Inspection Service (FSIS) says you should get rid of it.
According to the FSIS, some molds can cause allergic reactions and respiratory problems. And a few molds can even produce “mycotoxins” in certain conditions—these are poisonous substances that can make people sick.
“When a food shows heavy mold growth, ‘root’ threads have invaded it deeply. In dangerous molds, poisonous substances are often contained in and around these threads,” the FSIS explains. “In some cases, toxins may have spread throughout the food … Moldy foods may also have bacteria growing along with the mold.”
If you have consumed moldy food and develop symptoms like shortness of breath, nausea, high fever, or diarrhea, you should seek medical attention as soon as possible, according to the Cleveland Clinic. “Be mindful of the fact that you ate it,” dietitian Lillian Craggs-Dino, DHA, told the health site. “And make sure you don’t have any symptoms for the rest of that day.”
RELATED: For more up-to-date information, sign up for our daily newsletter.
Kiah says a worker revealed that the food was expired after the fact.

After noticing the condition of her Slim Jim, Kiah said she returned to the Family Dollar store that sold her the product. “I went back into that store and I said ‘ma’am, look at this Slim Jim. This Slim Jim is moldy and old,'” she recalled.
According to Kiah, the worker responded by telling her she forgot to “check that box” that morning. But when the Family Dollar employee went to check while Kiah was there, she said the expiration date was listed as Nov. 26, 2022.
“So you mean to tell me this Slim Jim has been sitting … in that box for almost a month? A month! I ate this Slim Jim,” Kiah said. “My three-year-old son who loves Slim Jims almost ingesting this disgusting Slim Jim. I’m lost for words right now. Y’all need to blow this up for me. Blow this up for me because this is a lawsuit. Like, do y’all see this? I’m not tripping, I’m not over-exaggerating … I’m beyond disgusted, and I hope I don’t get sick over this.”
Best Life reached out to Family Dollar about the alleged incident, but has not yet heard back.
Family Dollar has been cited for selling expired products in the past.

This is not the first time Family Dollar has found itself in hot water over expired items. Back in 2019, Family Dollar and its sister chain Dollar Tree were ordered by the New York Attorney General’s office to pay $1.2 million in fines and damages alongside Dollar General for selling products past their expiration dates.
According to a press release, investigators for the New York State Office of the Attorney General started going undercover in March 2016 to inspect the shelves of dollar stores in the state for expired products. “At a number of Dollar General, Dollar Tree, and Family Dollar stores, investigators found over-the-counter drugs that were months beyond their expiration dates,” the report said.
